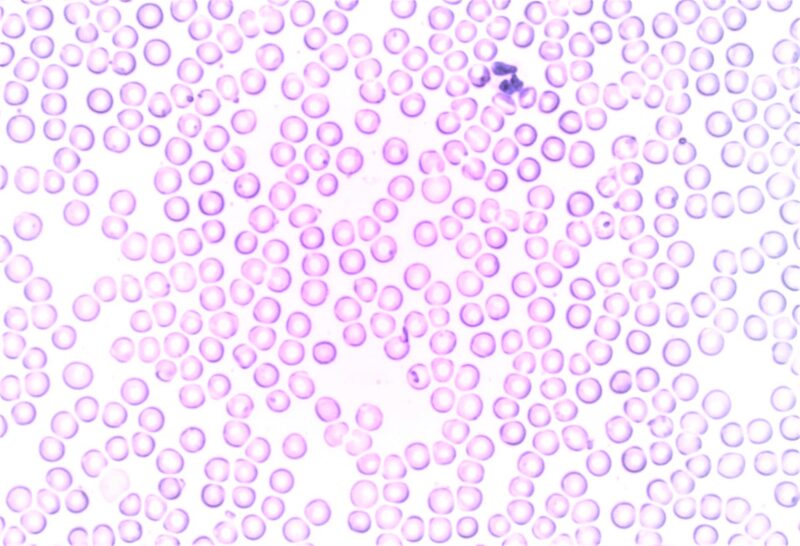
Teoría endosimbiótica

Últimos artículos

Cetáceos
Se les llama cetáceos a los animales acuáticos que integran el...

Centrosoma
El centrosoma o citocentro es un orgánulo existente en las...

Agricultura
La agricultura es el arte y la ciencia de poder cultivar...

Arboricultura
La arboricultura es un tipo de ciencia que se encarga de...

Pastoreo
El pastoreo es un tipo de sistema de subsistencia por...

Ganadería
La ganadería es un tipo de actividad económica que se...

Viticultura
La viticultura es una ciencia, el estudio y la práctica del...

Teoría quimiosintética
La teoría quimiosintética postula que bajo las condiciones de la...
Teoría endosimbiótica
La teoría endosimbiótica dice que el origen de las células...

Horticultura
La horticultura es una ciencia y al mismo tiempo un...

Teoría celular
La teoría celular es una parte fundamental de la biología que...

Ovocito
Un ovocito es un tipo de célula germinal que se encuentra en las...